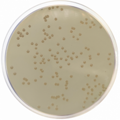
E-shop hlavní obrázek

Mechanická pipeta jednokanálová s nastavitelným objemem 500 - 5000 µl

Mechanická pipeta jednokanálová s nastavitelným objemem 2 - 20 µl

Rychle a snadno prozkoumejte a vyhodnoťte své živé buňečné kultury.

Rychlý imunochromatografický test pro kvalitativní detekci antigenu seroskupiny 1 Legionella pneumophila ve vzorku moči.

Sabouraud chloramphenicol gentamicin agar je selektivní kultivační půda, která se používá pro kultivaci dermatofytů.

Sterilní lyofilizovaný doplněk pro selektivní izolaci bakterií druhu Yersinia enterocolitica.

Médium pro selektivní obohacování Salmonella spp. a některých kmenů Shigella ve výkalech, moči (z klinických vzorků) a dalších hygienicky významných materiálech. Tento produkt je dodáván v dehydratované formě a je určen pro přípravu hotových kultivačních médií.

Sterilní PCR-ready pipetovací špičky bez filtru s prémiovým povrchem a rozsahem 0,1-200 µl, autoklávovatelné při teplotě 121 °C.

Prémiové sterilní pipetovací PCR-ready špičky s filtrem a rozsahem 0-100 µl, autoklávovatelná při teplotě 121 °C.
Půda určená pro detekci citlivosti na antimikrobiální látky rodu Haemophilus influenzae. Tento produkt je dodáván v dehydratované formě a je určen pro přípravu hotových kultivačních médií.

Testovací sérum Anti-Salmonella H je určen pro použití při identifikaci nebo ověření H-antigenů kmenů Salmonella. Umožňují určení sérovarů.

Testovací sérum Anti-Salmonella H je určen pro použití při identifikaci nebo ověření H-antigenů kmenů Salmonella. Umožňují určení sérovarů.

Testovací sérum Anti-Salmonella H je určen pro použití při identifikaci nebo ověření H-antigenů kmenů Salmonella. Umožňují určení sérovarů.

Používané pro zkoušky sterility a pro kultivaci Clostridium perfringens. Tento produkt je dodáván v dehydratované formě a je určen pro přípravu hotových kultivačních médií.

MIC Test stripy jsou určeny pro kvantitativní stanovení minimální inhibiční koncentrace (MIC) antimikrobiálních látek proti mikroorganismům a pro detekci mechanismů rezistence.
Kalibrační set vhodný pro použití při kvantitativním in vitro stanovení lipoproteinu (a) Lp(a) fotometricky.

AESKULISA tTg-A je enzymoimuno-analytická souprava pro kvantitativní a kvalitativní detekci protilátek proti tkáňové transglutamináze (tTg) v lidském séru.

Ebulioskopický osmometr VAPRO stanovuje osmolalitu v různých typech vzorků, včetně těch s velkou viskozitou nebo vzorků tkání.